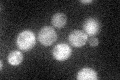
YGR134W
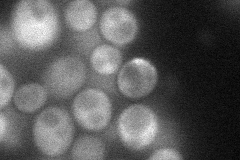
YGR134W
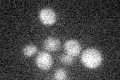
YGR134W

View description
Part of the evolutionarily-conserved CCR4-NOT transcriptional regulatory complex involved in controlling mRNA initiation, elongation, and degradation
Localization:
Intensity:
Fold change:
Significance:
-
C’ GFP library in SD
cytosol23.91 -
N' NOP1pr-GFP in SD
cytosol37.625 -
N' TEF2pr-mCherry in SD

cytosol,punctate28.5103 -
N' NATIVEpr-GFP in SD

below threshold17.8532 -
N' TEF2pr-VC and Cyto-VN in SD

below threshold27.1031 -
C’ GFP library in SD+DTT

cytosol24.341.01No -
C’ GFP library in SD+H2O2

cytosol26.191.09No -
C’ GFP library in Starvation Media
cytosol19.20.8No -
C’ GFP library on the background of Pup2-DaMP

cytosol -
C’ GFP library on the background of CCT mutant

cytosol24.93441.04253No
